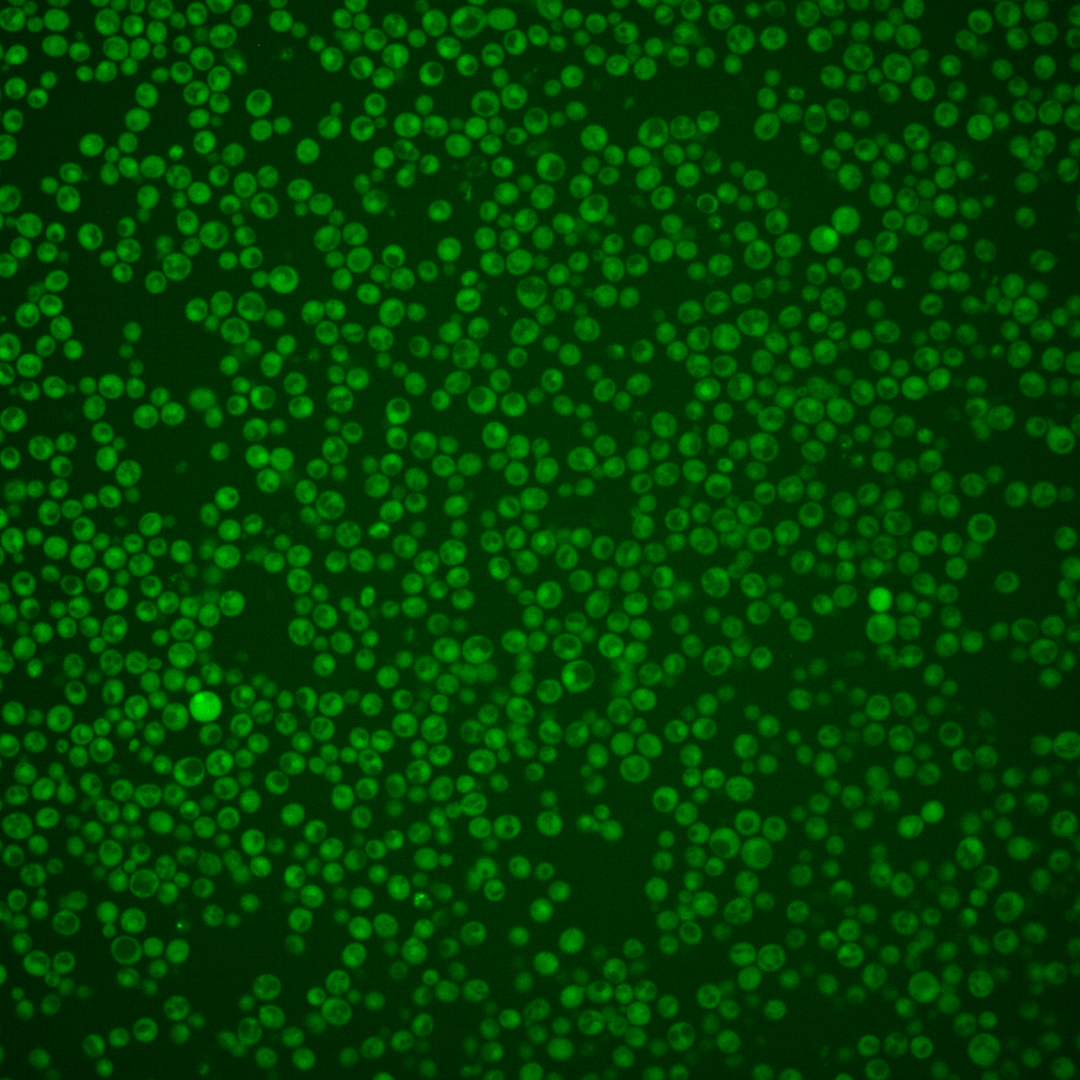

| Standard name | |
|---|---|
| Human Ortholog | |
| Description | Protein kinase similar to S/T protein kinase Ypk1p; functionally redundant with YPK1 at the genetic level; participates in a signaling pathway required for optimal cell wall integrity; involved in the TORC-dependent phosphorylation of ribosomal proteins Rps6a/b (S6); human homolog SGK2 can complement a ypk1 ypk2 double mutant |
Micrographs




















































































Sub-cellular Localization
Yeast GFP Assignment
Protein Abundance
Localization Change
External localization resources
| ensLOC | DeepLoc | |||||||||||||||||||||||
|---|---|---|---|---|---|---|---|---|---|---|---|---|---|---|---|---|---|---|---|---|---|---|---|---|
| Localization | WT1 | WT2 | WT3 | RAP60 | RAP140 | RAP220 | RAP300 | RAP380 | RAP460 | RAP540 | RAP620 | RAP700 | HU80 | HU120 | HU160 | rpd3Δ_1 | rpd3Δ_2 | rpd3Δ_3 | WT1 | WT2 | WT3 | AF100 | AF140 | AF180 |
| Cortical Patches | 0 | 0 | 1 | 0 | 0 | 0 | 0 | – | 0 | 1 | 1 | 0 | 0 | 0 | 0 | 0 | 0 | 0 | 0 | 3 | 0 | 0 | 1 | 1 |
| Bud | 0 | 1 | 0 | 0 | 0 | 2 | 0 | – | 1 | 4 | 2 | 2 | 0 | 0 | 0 | 0 | 0 | 0 | 0 | 2 | 1 | 1 | 2 | 6 |
| Bud Neck | 0 | 0 | 0 | 0 | 0 | 0 | 0 | – | 0 | 0 | 0 | 0 | 0 | 0 | 0 | 0 | 0 | 0 | 0 | 0 | 0 | 0 | 0 | 1 |
| Bud Site | 0 | 0 | 0 | 0 | 0 | 0 | 0 | – | 0 | 0 | 0 | 0 | 0 | 0 | 0 | 0 | 0 | 0 | – | – | – | – | – | – |
| Cell Periphery | 0 | 4 | 3 | 3 | 0 | 5 | 3 | – | 6 | 2 | 3 | 4 | 0 | 2 | 3 | 7 | 9 | 7 | 0 | 0 | 0 | 0 | 0 | 0 |
| Cytoplasm | 200 | 301 | 224 | 226 | 269 | 273 | 363 | – | 193 | 240 | 188 | 191 | 335 | 478 | 473 | 134 | 191 | 147 | 190 | 293 | 212 | 117 | 324 | 377 |
| Endoplasmic Reticulum | 0 | 6 | 0 | 2 | 1 | 0 | 0 | – | 0 | 2 | 2 | 12 | 0 | 2 | 2 | 6 | 7 | 3 | 0 | 1 | 1 | 0 | 1 | 1 |
| Endosome | 0 | 0 | 0 | 0 | 1 | 0 | 0 | – | 0 | 1 | 1 | 0 | 0 | 0 | 0 | 1 | 2 | 0 | 0 | 2 | 1 | 1 | 1 | 2 |
| Golgi | 0 | 0 | 0 | 0 | 1 | 0 | 0 | – | 0 | 0 | 0 | 0 | 0 | 0 | 1 | 0 | 1 | 0 | 0 | 1 | 0 | 1 | 1 | 0 |
| Mitochondria | 0 | 2 | 0 | 2 | 3 | 19 | 33 | – | 49 | 42 | 76 | 42 | 0 | 0 | 0 | 3 | 3 | 2 | 2 | 2 | 2 | 1 | 4 | 1 |
| Nucleus | 2 | 2 | 1 | 0 | 1 | 4 | 9 | – | 5 | 11 | 9 | 12 | 1 | 2 | 0 | 7 | 3 | 2 | 0 | 1 | 0 | 0 | 1 | 0 |
| Nuclear Periphery | 0 | 1 | 0 | 0 | 0 | 0 | 0 | – | 2 | 2 | 3 | 1 | 0 | 0 | 0 | 0 | 2 | 0 | 0 | 0 | 0 | 0 | 0 | 0 |
| Nucleolus | 0 | 1 | 0 | 0 | 0 | 0 | 1 | – | 2 | 0 | 0 | 0 | 1 | 0 | 0 | 0 | 0 | 0 | 0 | 0 | 0 | 0 | 0 | 0 |
| Peroxisomes | 0 | 0 | 0 | 0 | 0 | 0 | 0 | – | 0 | 0 | 0 | 0 | 0 | 0 | 0 | 1 | 0 | 0 | 0 | 1 | 0 | 0 | 0 | 0 |
| SpindlePole | 0 | 0 | 0 | 0 | 0 | 1 | 0 | – | 0 | 1 | 0 | 0 | 0 | 0 | 0 | 0 | 0 | 0 | 0 | 1 | 0 | 0 | 2 | 2 |
| Vac/Vac Membrane | 0 | 2 | 2 | 2 | 13 | 14 | 18 | – | 11 | 16 | 3 | 13 | 1 | 2 | 0 | 5 | 15 | 7 | 1 | 1 | 1 | 0 | 1 | 3 |
| Unique Cell Count | 202 | 313 | 226 | 229 | 283 | 295 | 407 | 246 | 294 | 250 | 252 | 336 | 480 | 477 | 143 | 206 | 153 | 196 | 318 | 227 | 128 | 347 | 403 | |
| Labelled Cell Count | 202 | 320 | 231 | 235 | 289 | 318 | 427 | 269 | 322 | 288 | 277 | 338 | 486 | 479 | 164 | 233 | 168 | 196 | 318 | 227 | 128 | 347 | 403 | |
Yeast GFP Assignment
Protein Abundance
| Screen | WT1 | WT2 | WT3 | RAP60 | RAP140 | RAP220 | RAP300 | RAP380 | RAP460 | RAP540 | RAP620 | RAP700 | HU80 | HU120 | HU160 | rpd3Δ_1 | rpd3Δ_2 | rpd3Δ_3 | AF100 | AF140 | AF180 |
|---|---|---|---|---|---|---|---|---|---|---|---|---|---|---|---|---|---|---|---|---|---|
| Mean Cell GFP Intensity (1e-4) | 5.8 | 6.6 | 7.0 | 6.4 | 7.3 | 6.0 | 6.2 | – | 5.6 | 5.8 | 5.1 | 5.5 | 6.7 | 7.0 | 6.8 | 8.3 | 8.4 | 8.2 | 6.3 | 7.0 | 7.5 |
| Std Deviation (1e-4) | 0.6 | 0.9 | 1.1 | 1.4 | 1.5 | 1.2 | 1.5 | – | 1.5 | 1.2 | 1.3 | 1.3 | 0.9 | 1.1 | 1.1 | 1.6 | 1.7 | 1.9 | 1.4 | 1.3 | 1.3 |
| Intensity Change (Log2) | – | – | – | -0.13 | 0.06 | -0.22 | -0.17 | – | -0.33 | -0.27 | -0.44 | -0.34 | -0.07 | 0.01 | -0.04 | 0.25 | 0.26 | 0.24 | -0.15 | 0.0 | 0.1 |
Localization Change
| Localization | RAP60 | RAP140 | RAP220 | RAP300 | RAP380 | RAP460 | RAP540 | RAP620 | RAP700 | HU80 | HU120 | HU160 | rpd3Δ_1 | rpd3Δ_2 | rpd3Δ_3 |
|---|---|---|---|---|---|---|---|---|---|---|---|---|---|---|---|
| Cortical Patches | 0 | 0 | 0 | 0 | – | 0 | 0 | 0 | 0 | 0 | 0 | 0 | 0 | 0 | 0 |
| Bud | 0 | 0 | 0 | 0 | – | 0 | 0 | 0 | 0 | 0 | 0 | 0 | 0 | 0 | 0 |
| Bud Neck | 0 | 0 | 0 | 0 | – | 0 | 0 | 0 | 0 | 0 | 0 | 0 | 0 | 0 | 0 |
| Bud Site | 0 | 0 | 0 | 0 | – | 0 | 0 | 0 | 0 | 0 | 0 | 0 | 0 | 0 | 0 |
| Cell Periphery | 0 | 0 | 0 | 0 | – | 0 | 0 | 0 | 0 | 0 | 0 | 0 | 0 | 1.9 | 0 |
| Cytoplasm | -0.4 | -2.6 | -3.5 | -4.6 | – | -7.0 | -6.4 | -7.6 | -7.5 | 0.9 | 0.8 | 0.1 | -3.0 | -3.4 | -2.0 |
| Endoplasmic Reticulum | 0 | 0 | 0 | 0 | – | 0 | 0 | 0 | 3.3 | 0 | 0 | 0 | 0 | 0 | 0 |
| Endosome | 0 | 0 | 0 | 0 | – | 0 | 0 | 0 | 0 | 0 | 0 | 0 | 0 | 0 | 0 |
| Golgi | 0 | 0 | 0 | 0 | – | 0 | 0 | 0 | 0 | 0 | 0 | 0 | 0 | 0 | 0 |
| Mitochondria | 0 | 0 | 3.9 | 4.4 | – | 7.1 | 5.9 | 9.0 | 6.4 | 0 | 0 | 0 | 0 | 0 | 0 |
| Nucleus | 0 | 0 | 0 | 0 | – | 0 | 2.5 | 0 | 2.9 | 0 | 0 | 0 | 0 | 0 | 0 |
| Nuclear Periphery | 0 | 0 | 0 | 0 | – | 0 | 0 | 0 | 0 | 0 | 0 | 0 | 0 | 0 | 0 |
| Nucleolus | 0 | 0 | 0 | 0 | – | 0 | 0 | 0 | 0 | 0 | 0 | 0 | 0 | 0 | 0 |
| Peroxisomes | 0 | 0 | 0 | 0 | – | 0 | 0 | 0 | 0 | 0 | 0 | 0 | 0 | 0 | 0 |
| SpindlePole | 0 | 0 | 0 | 0 | – | 0 | 0 | 0 | 0 | 0 | 0 | 0 | 0 | 0 | 0 |
| Vacuole | 0 | 2.5 | 2.5 | 2.4 | – | 2.4 | 2.8 | 0 | 2.7 | 0 | 0 | 0 | 0 | 3.4 | 0 |
External localization resources
Images






























Protein Concentration and Protein Localization Data
| R1 | R2 | R3 | ||||||||||||||||
|---|---|---|---|---|---|---|---|---|---|---|---|---|---|---|---|---|---|---|
| G1 Pre-START | G1 Post-START | S/G2 | Metaphase | Anaphase | Telophase | G1 Pre-START | G1 Post-START | S/G2 | Metaphase | Anaphase | Telophase | G1 Pre-START | G1 Post-START | S/G2 | Metaphase | Anaphase | Telophase | |
| Concentration | – | – | – | – | – | – | – | – | – | – | – | – | – | – | – | – | – | – |
| Actin | 0.0034 | 0.001 | 0.0013 | 0.0012 | 0.0079 | 0.0026 | 0.0205 | 0.0017 | 0.0025 | 0.0006 | 0.0062 | 0.0044 | – | – | – | – | – | – |
| Bud | 0.0001 | 0.0307 | 0.0597 | 0.0003 | 0.0003 | 0.0035 | 0.0021 | 0.0129 | 0.0137 | 0.0001 | 0.0005 | 0.0001 | – | – | – | – | – | – |
| Bud Neck | 0.0002 | 0.0001 | 0.0004 | 0.0004 | 0.0005 | 0.0023 | 0.0012 | 0.0003 | 0.0004 | 0.0003 | 0.0015 | 0.0012 | – | – | – | – | – | – |
| Bud Periphery | 0.0001 | 0.0073 | 0.0206 | 0.0002 | 0.0002 | 0.0028 | 0.0021 | 0.005 | 0.009 | 0.0001 | 0.0005 | 0.0001 | – | – | – | – | – | – |
| Bud Site | 0.0006 | 0.0234 | 0.0345 | 0.0001 | 0.0016 | 0.0001 | 0.0131 | 0.0134 | 0.005 | 0.0002 | 0.0005 | 0.0001 | – | – | – | – | – | – |
| Cell Periphery | 0.0002 | 0.0006 | 0.0008 | 0.0001 | 0.0001 | 0.0004 | 0.0002 | 0.0002 | 0.0001 | 0 | 0.0001 | 0 | – | – | – | – | – | – |
| Cytoplasm | 0.4542 | 0.6735 | 0.4483 | 0.572 | 0.4006 | 0.6742 | 0.0291 | 0.4384 | 0.403 | 0.2751 | 0.1418 | 0.5045 | – | – | – | – | – | – |
| Cytoplasmic Foci | 0.0457 | 0.0028 | 0.0093 | 0.0074 | 0.0855 | 0.0138 | 0.1047 | 0.0096 | 0.0094 | 0.0084 | 0.0196 | 0.0176 | – | – | – | – | – | – |
| Eisosomes | 0.0002 | 0.0001 | 0.0001 | 0.0001 | 0 | 0.0001 | 0.0002 | 0 | 0 | 0 | 0 | 0 | – | – | – | – | – | – |
| Endoplasmic Reticulum | 0.0349 | 0.0028 | 0.0016 | 0.0011 | 0.0014 | 0.0023 | 0.0111 | 0.0026 | 0.0016 | 0.0083 | 0.0011 | 0.0017 | – | – | – | – | – | – |
| Endosome | 0.0588 | 0.0003 | 0.0008 | 0.0016 | 0.0757 | 0.001 | 0.2573 | 0.0024 | 0.003 | 0.0164 | 0.0884 | 0.0199 | – | – | – | – | – | – |
| Golgi | 0.0147 | 0.0001 | 0.0001 | 0.0022 | 0.1127 | 0.0001 | 0.0428 | 0.0005 | 0.003 | 0.0027 | 0.0632 | 0.0016 | – | – | – | – | – | – |
| Lipid Particles | 0.031 | 0.0003 | 0.0002 | 0.0336 | 0.032 | 0.0002 | 0.0704 | 0.0007 | 0.0005 | 0.0095 | 0.004 | 0.001 | – | – | – | – | – | – |
| Mitochondria | 0.0023 | 0.0005 | 0.0014 | 0.0039 | 0.0057 | 0.0003 | 0.0219 | 0.0007 | 0.0016 | 0.0256 | 0.0115 | 0.0011 | – | – | – | – | – | – |
| None | 0.2805 | 0.2516 | 0.4071 | 0.3543 | 0.265 | 0.2847 | 0.2724 | 0.4936 | 0.4985 | 0.6282 | 0.6537 | 0.3989 | – | – | – | – | – | – |
| Nuclear Periphery | 0.0286 | 0.0006 | 0.001 | 0.0012 | 0.0004 | 0.0012 | 0.032 | 0.0019 | 0.0023 | 0.0076 | 0.0007 | 0.0017 | – | – | – | – | – | – |
| Nucleolus | 0.0006 | 0.0002 | 0.0007 | 0.0002 | 0.0001 | 0.0004 | 0.0023 | 0.0003 | 0.0006 | 0.0002 | 0.0001 | 0.0005 | – | – | – | – | – | – |
| Nucleus | 0.0069 | 0.0023 | 0.0055 | 0.0018 | 0.0003 | 0.0043 | 0.0083 | 0.0084 | 0.0197 | 0.0086 | 0.0009 | 0.0217 | – | – | – | – | – | – |
| Peroxisomes | 0.0262 | 0.0001 | 0.0002 | 0.0146 | 0.0073 | 0 | 0.0668 | 0.0026 | 0.0105 | 0.0021 | 0.0018 | 0.0022 | – | – | – | – | – | – |
| Punctate Nuclear | 0.0068 | 0.0007 | 0.0052 | 0.0032 | 0.0007 | 0.0049 | 0.0257 | 0.004 | 0.0146 | 0.0034 | 0.0007 | 0.0204 | – | – | – | – | – | – |
| Vacuole | 0.0028 | 0.0008 | 0.0011 | 0.0005 | 0.0012 | 0.0008 | 0.0107 | 0.0008 | 0.0007 | 0.0014 | 0.0019 | 0.001 | – | – | – | – | – | – |
| Vacuole Periphery | 0.0013 | 0.0001 | 0.0002 | 0.0002 | 0.0008 | 0.0001 | 0.0052 | 0.0001 | 0.0001 | 0.0013 | 0.0013 | 0.0004 | – | – | – | – | – | – |
Sequencing Data
| R1 | R2 | |||||||||
|---|---|---|---|---|---|---|---|---|---|---|
| G1 Post-START | S/G2 | Metaphase | Anaphase | Telophase | G1 Post-START | S/G2 | Metaphase | Anaphase | Telophase | |
| Gene Expression | 5.696 | 8.244 | 5.7576 | 8.992 | 7.0335 | 6.5062 | 9.1936 | 8.9353 | 11.4876 | 9.6617 |
| Translational Efficiency | 0.3641 | 0.3754 | 0.5947 | 0.4316 | 0.404 | 0.6564 | 0.5057 | 0.6161 | 0.444 | 0.4873 |
Hit Data
| Dataset | Hit |
|---|---|
| Protein Concentration | – |
| Protein Localization | ✘ |
| Gene Expression | ✘ |
| Translational Efficiency | ✘ |
Endocytosis
| Temp | Actin Patch (Sac6-tdTomato) | Cortical Patch (Sla1-GFP) | Late Endosome (Snf7-GFP) | Vacuole (Vph1-GFP) |
|---|---|---|---|---|
| 37℃ | ||||
| RT |
Cell Cycle Omics
CYCLoPs (Ypk2-GFP)
| Gene / Allele | Actin Patch (Sac6-tdTomato) | Cortical Patch (Sla1-GFP) | Late Endosome (Snf7-GFP) | Vacuole (Sac6-tdTomato) |
|---|
| Gene | Images |
|---|
| Gene | Images |
|---|
Images are not yet available
Images are not yet available